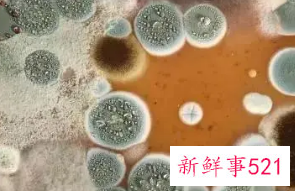
微生物生态学

微信扫码关注
微信扫码关注看新鲜资讯

 微信扫码关注
微信扫码关注微生物生态学
微生物生态学,我们都知道我们的生活中共充满了为生物,很多都是肉眼不可见的,微生物在我们生活中无处不在,体内的有益菌,体外的各种细菌,都是微生物,以下为大家分享微生物生态学。
微生物生态学概述
在生物进化过程中,微生物与其宿主(人、动物、植物及微生物)、微生物及微生物以及他们与环境之间,由于长期相互适应的结果,在正常情况下,生物宿主的体表与体内分布着一定种类和数量的,形成一个生态系并保持生态平衡的特定微生物群,称之为正常菌群(Normal Flora)。
正常菌群分布于人体体表以及与外界相通的腔道,分布部位有皮肤、呼吸道、外耳道、消化道(口腔;胃;空肠;回肠;结肠)、鼻腔、泌尿生殖道等,其中以肠道最多。这些微生物在长期的进化过程中和人形成共生关系。许多微生物对人不仅无害,而且有益。
正常菌群中以肠道菌群最具有代表性 ,研究最有成效。肠道菌群总数可达为1014个细菌,为人体细胞总数的10~20倍
其中至少包括14个菌属(类杆菌、双歧杆菌、乳杆菌消化球菌、消化链球菌、肠球菌、肠杆菌等),约400~500种细菌,90%~99.9%是厌氧菌(双岐杆菌、乳杆菌等)肠杆菌、肠球菌等需氧菌数量极少。

正常菌群有许多重要的生理功能:
1、如菌群之间生物的拮抗作用,正常菌群在人体某一特定位粘附,定植和繁殖,形成一层菌膜屏障。通过拮抗作用,抑制并排斥过路菌群的入侵和群集,调整人体与微生物之间的平衡状态。
2、免疫作用,正常菌群能刺激宿主产生免疫及清除功能。
3、排毒作用,如双岐杆菌能使肠道过多的革兰氏阴性杆菌下降到正常水平,减少内毒素的吸收。
4、抗肿瘤作用,能降解、清除体内的致癌因子,激活体内的抗肿瘤细胞因子等。
5、抗衰老作用等。肠道菌群除了上述以上功能之外,对人体还有营养作用,人体肠道的正常微生物,如双岐杆菌,乳酸杆菌等能合成多种人体生长发育必须的维生素,如B族维生素(维生素B1、B2、B6、B12),维生素K,烟酸、泛酸等
还能利用蛋白质残渣合成非必需氨基酸,如天冬门氨酸、丙氨酸、缬氨酸和苏氨酸等,并参与糖类和蛋白质的代谢,同时还能促进铁、镁、锌等矿物元素的吸收。浙江大学医学院附属儿童医院消化内科楼金

微生态学是研究人体内正常微生物的结构、功能以及与其宿主相互关系的学科,是生命学的重要组成部分。最早由1977年德国Volker Rush提出了微生态学,经过30年的发展,微生态学研究取得了长远的发展,其中微生态制剂在临床的广泛应用是微生态学发展的重要成果之一。
微生态制剂又称为益生剂,是利用正常微生物成员或促微生物生长的`物质所制备的制剂,它通过调整或维持微生态平衡,达到防治疾病,增进健康的目的。按微生态制剂的物质组成可以分为益生菌(Probiotics)、益生元(Prebiotics)、合生元(Synbiotics)三类。
益生菌是指改善宿主微生态平衡而发挥有益作用,达到提高宿主健康水平和健康状态的活菌制剂及其代谢产物,益生菌存在于地球上的各各角落里面,动物体内有益的细菌或真菌主要有:乳酸菌、双歧杆菌、放线菌、酵母菌等。
益生元是指一种非消化性食物成分,能选择性促进肠内有益菌群的活性或生长繁殖,起到促进宿主健康和促生长作用。最早发现的益生元是双歧因子。后来又发现多种不能消化的寡糖可作益生元。
最常见的寡糖有乳果糖、蔗糖寡聚糖、棉籽寡聚糖及寡聚麦芽糖等。这些寡糖不被有害细菌分解和利用,只能被有益菌利用,促进有益菌生长,达到调整菌群的目的。近年来,我国研究发现,一些中草药制剂也可作为益生元。
益生元有许多优越性,不存在保持活菌数的技术难关,稳定性强,有效期长,不仅可促进有益菌群生长,而且还可提高机体免疫功能。合生元为益生菌和益生元结合的生物制剂,它的特点是同时发挥益生菌和益生元的作用。这种制剂的应用,有日渐增多的趋势。
生态学(Ecology)是研究有机体及其周围环境相互关系的科学。
生物的生存、活动、繁殖需要一定的空间、物质与能量。生物在长期进化过程中,逐渐形成对周围环境某些物理条件和化学成分,如空气、光照、水分、热量和无机盐类等的特殊需要。各种生物所需要的物质、能量以及它们所适应的理化条件是不同的,这种特性称为物种的生态特性。

任何生物的生存都不是孤立的:同种个体之间有互助有竞争;植物、动物、微生物之间也存在复杂的相生相克关系。人类为满足自身的需要,不断改造环境,环境反过来又影响人类。
随着人类活动范围的扩大与多样化,人类与环境的关系问题越来越突出。因此近代生态学研究的范围,除生物个体、种群和生物群落外,已扩大到包括人类社会在内的多种类型生态系统的复合系统。人类面临的人口、资源。环境等几大问题都是生态学的研究内容。
微生物是怎么生长的
我们都知道新鲜蔬菜被晒干后就不容易腐烂了,这是因为蔬菜的水分减少了,引起蔬菜腐烂的微生物就不容易生长。微生物的生长必须有水
但结合在分子内的水不能被微生物利用,只有游离的水才能被利用。采用“水活度”值这一概念来表示能被微生物利用的实际含水量,微生物所需要的水活度越高, 在干燥的环境下就越不容易生长。
微生物细胞在合适的环境条件下,会不断获取外界的营养物质。这些营养物质在细胞内发生各种化学变化,有些被作为能源消耗了,有些变成了细胞自身的结构组织
如果变成细胞组织的物质多于被消耗掉的物质,细胞物质的总量就会不断增加,细胞个体就会长大.在达到一定程度时,就会繁殖,即由一个细胞变成两个,两个变成四.....最后发展成一个群体。
微生物惊人的繁殖速度
微生物的生长繁殖速度是惊人的。我们知道,高等生物完成一个世代交替的周期要几年甚至几十年,而微生物完成世代交替只需要几分钟。细菌增殖的方式是二分裂法,即以2的n次方递增,拿大肠杆菌来说,大肠杆菌在适宜温度时20分钟即形成一代,24小时则繁殖72代。
当然,因为地球上任何生物都要受到物质条件及其他相关条件的制约,不可能无限繁殖,不过,也确实由于许多致病微生物有着惊人的繁殖速度,才使得我们的医疗手段在它们面前无能为力。
细菌如此,其他微生物也是如此。更有甚者是病毒,它们增殖的方法是复制,就像我们翻录磁带一样。病毒在它们所寄生的细胞中,只需按照自己的模样,利用细胞中的各种原料和酶无休止地复制后代个体,直到被寄生的细胞变成空壳为止。
至此,它们从这细胞中破壳而出,一次出来就是上亿个细菌!然后再分别去感染临近的其他细胞,复制新一代的个体。如此,在极短的时间内就可产生数量极多的后代,这也是高等生物自叹不如的。
正是微生物有这样神奇的本领,才得以在地球漫长的进行过程中保存下来,而许多较高等的生物却只能在地球上走过短短的进化年代便销声匿迹了。

到哪里获取营养成分
营养是微生物生长的先决条件。
在自然界中,微生物从其生存环境中获取生长所需的各种营养成分。在土壤中,各种有机质是异养微生物细菌、放线菌、霉菌生长所需的碳源和能源。
在茂密的丛林中,枯枝败叶是各种土著微生物赖以生长的天然粮库。许多大型真菌生活在草地上、树干上,甚至是腐木上,有些则是与树木的根部共生,它们的营养方式为腐生、寄生,或二者兼而有之。
微生物也在相互“竞争"
面对饥饿或病毒,微生物会作出什么反应呢。一部分微生物会形成孢子,将DNA (脱氧核糖核酸)封闭起来,使母细胞死亡,这确保了整个菌群的生存。一旦威胁消除,孢子萌发,菌群重新生长繁殖。
在此过程中,微生物还要选择是否进入一种“竞争”状态,即通过改变细胞膜,以更容易吸收来自邻近其他死亡细胞的物质。如此一来,在生存压力消失后,这些微生物可以更快地恢复正常生活。
雅各布教授认为,这是一个艰难的选择,甚至可以说是一场赌博,因为只有当其他微生物进人到孢子休眠状态时,形势才对进人到“竞争”状态的微生物有利。观测显示,只有约10%的微生物进人到“竞争”状态。为什么不是所有的微生物同时进人到“竞争”状态呢?
这是因为微生物不会向自己的同伴隐瞒自已的意图,也不会说谎或推诿,它们之间可通过发送化学信息来传递个体的意图。个体微生物根据所面对的生存压力、同伴的处境、有多少细胞处于休眠状态以及有多少细胞处于“竞争”状态,来仔细权衡,最终决定个体的状态。
对环境的适应
我们知道,鸡蛋只有在适合的温度下才能孵化成小鸡,这是因为在细胞中进行的生物化学反应是生命活动的基础,而这些反应需要在一"定的温度下进行。
对于大多数微生物来说,温度太低,不能进行营养物质的运输,也不利于各种生命过程的进行。在温度适当升高时,细胞内的生物化学反应速度加快,就能加速微生物的生长。当温度超过微生物所能忍受的极限时,就会导致其死亡。
当然,由于自然界的环境与生物种类的多样性,有些微生物能够在一般生物所不能生存的环境条件下生长,例如生活在南极和北极地区的嗜冷微生物、生活在高温环境中的嗜热微生物以及生长在热泉和火山喷口地区的嗜高热微生物等
推荐阅读

00后 JK妹子醉倒在小巷子内,被路过的小哥摁在地上撩开裙子
❤️猎奇❤️00后JK妹子醉倒在小巷子内,被路过的小哥摁在地上撩开裙子就是一顿猛操,还疯狂口爆,简直爽翻了!
2026-03-08

姐弟乱伦爆炸新闻 遭家人反对近亲相恋广州新闻大学王闪闪与
姐弟乱伦爆炸新闻 遭家人反对近亲相恋广州新闻大学王闪闪与亲舅舅儿子恋爱,自拍吃鸡吧后入挨操
2026-03-08

韶关碧桂园 丽枫酒店前台接待卖淫女 钟佩琪 患艾滋还接客被
韶关碧桂园丽枫酒店前台接待的卖淫女 钟佩琪 有艾滋病还频繁约炮卖淫,怪不得能同意无套呢!有一说一,这妹子颜值身材当真没得挑,口活做爱技术和服务程度也是一等一的绝,可惜了玩的太花太大胆,小小年纪就患了性病,
2026-03-08

乱伦合集【慈父和萝莉女儿甜甜】,乖女儿宽衣解带女上位被
乱伦合集,【慈父和萝莉女儿甜甜】,乖女儿宽衣解带女上位被内射流精,女儿还挺配合享受
2026-03-08

❤️极品反差婊❤️中南大学林雁被同学捆绑捂嘴强奸,并威
❤️极品反差婊❤️中南大学林雁被同学捆绑捂嘴强奸,并威胁说:不乱动,敢动我就划破你的脸!
2026-03-08